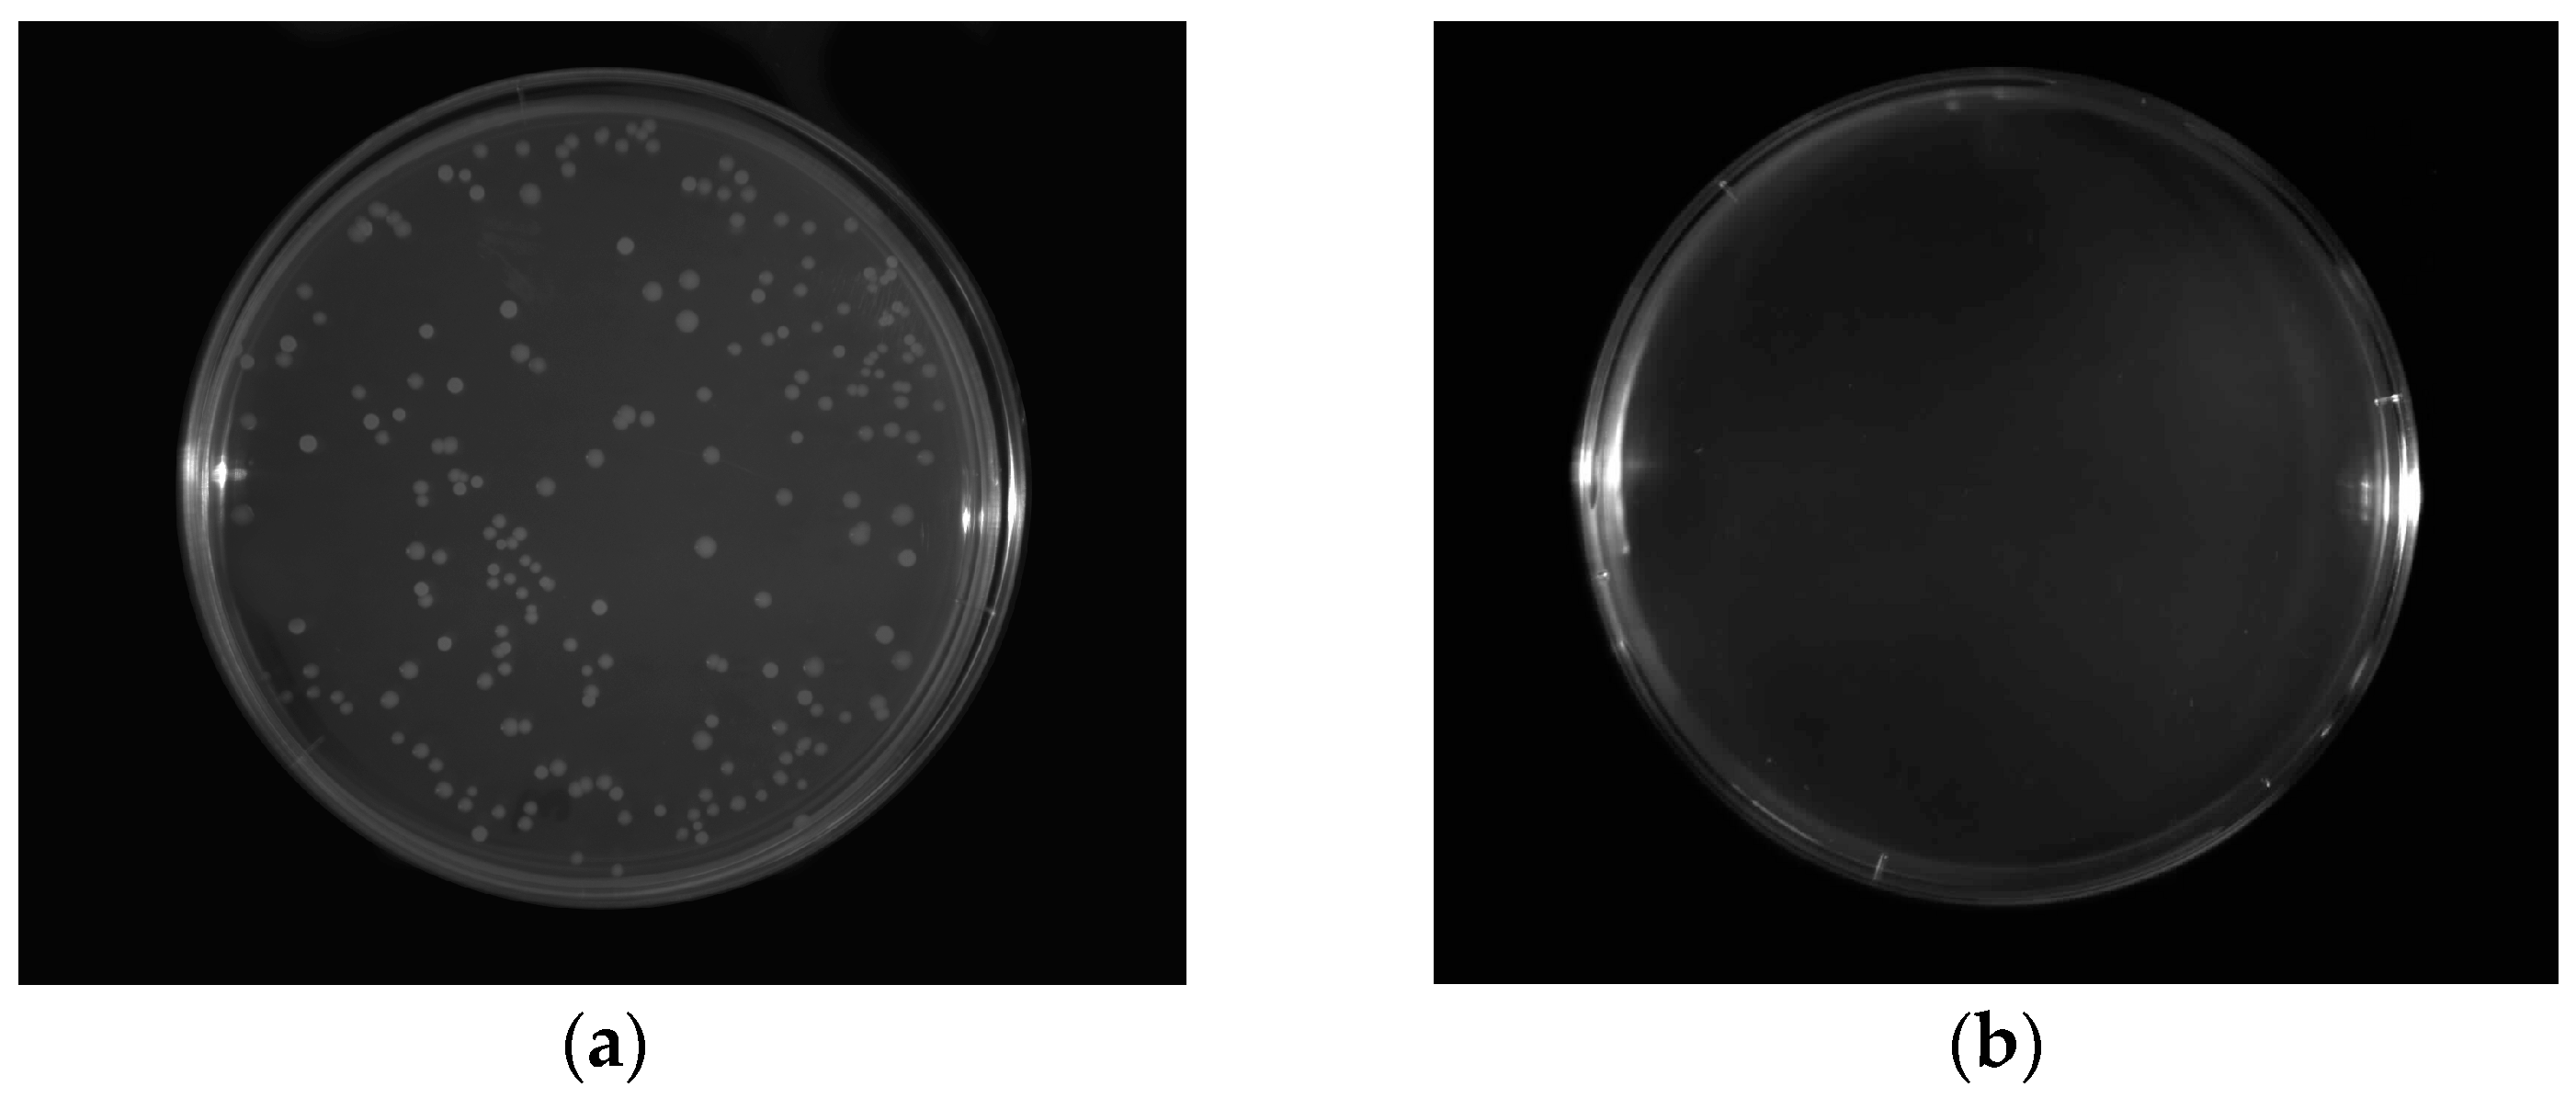
Ijms 17 01436 g003 1024

Antimicrobial and Antioxidant Activity of Chitosan/Hydroxypropyl Methylcellulose Film-Forming Hydrosols Hydrolyzed by Cellulase
Abstract
:1. Introduction
2. Results
2.1. Viscosity
2.2. Reducing Sugar-Ends Content
2.3. DPPH (2,2-Diphenyl-1-picrylhydrazyl)
2.4. Ferric Reducing Antioxidant Power (FRAP)
2.5. Antimicrobial Activity
3. Materials and Methods
3.1. Materials
3.2. Hydrosols Preparation
3.3. Viscosity Determination
3.4. Quantitive Determination of Reducing Sugar-Ends
3.5. Free Radical Scavenging Activity
3.6. Ferric Reducing Ion Antioxidant Power
3.7. Antimicrobial Activity
3.8. Statistical Analysis
4. Conclusions
Acknowledgments
Author Contributions
Conflicts of Interest
References
- Seo, S.; Kim, O.Y.; Shim, S. Using the theory of planned behavior to determine factors influencing processed foods consumption behavior. Nutr. Res. Pract. 2014, 8, 327–335. [Google Scholar] [CrossRef] [PubMed]
- Muñoz-Bonilla, A.; Fernández-García, M. The roadmap of antimicrobial polymeric materials in macromolecular nanotechnology. Eur. Polym. J. 2015, 65, 46–62. [Google Scholar] [CrossRef]
- Kruijf, N.; Beest, M.; Rijk, R.; Sipiläinen-Malm, T.; Losada, P.; Meulenaer, D. Active and intelligent packaging: Applications and regulatory aspects. Food Addit. Contam. 2002, 19, 144–162. [Google Scholar] [CrossRef]
- Baranenko, D.A.; Kolodyaznaya, V.S.; Zabelina, N.A. Effect of composition and properties of chitosan-Based edible coatings on microflora of meat and meat products. Acta Sci. Pol. Technol. Aliment. 2013, 12, 149–157. [Google Scholar]
- Coma, V. Bioactive packaging technologies for extended shelf life of meat-based products. Meat Sci. 2008, 78, 90–103. [Google Scholar] [CrossRef] [PubMed]
- Sagoo, S.; Board, R.; Roller, S. Chitosan inhibits growth of spoilage microorganisms in chilled pork products. Food Microbiol. 2002, 19, 175–182. [Google Scholar] [CrossRef]
- Tsai, G.J.; Su, W.H.; Chen, H.C.; Pan, C.L. Antimicrobial activity of shrimp chitin and chitosan from different treatments and applications of fish preservation. Fish. Sci. 2002, 68, 170–177. [Google Scholar] [CrossRef]
- No, H.K.; Park, N.Y.; Lee, S.H.; Meyers, S.P. Antibacterial activity of chitosans and chitosan oligomers with different molecular weights. Int. J. Food Microbiol. 2002, 74, 65–72. [Google Scholar] [CrossRef]
- Rabea, E.I.; Badawy, M.E.T.; Stevens, C.V.; Smagghe, G.; Steuerbaut, W. Chitosan as antimicrobial agent: Applications and mode of action. Biomacromolecules 2003, 4, 1457–1465. [Google Scholar] [CrossRef] [PubMed]
- Rodríguez, M.S.; Albertengo, L.; Debbaudt, A.; Agulló, E. Uso del quitosano en alimentos. In Nuevas Tecnologías de Conservación de Productos Frescos Cortados, 1st ed.; González, A.G.A., Gardea, A.A., Cuamea, N.F., Eds.; Logprint Digital: Mexico City, Mexico, 2005; pp. 391–392. [Google Scholar]
- Hadwiger, L.A.; Kendra, D.F.; Fristensky, B.W.; Wagoner, W. Chitosan both activates genes in plants and inhibit RNA synthesis in fungi. In Chitin in Nature and Technology, 1st ed.; Muzzarelli, R., Jeuniaux, C., Gooday, G.W., Eds.; Plenum Press: New York, NY, USA, 1986; pp. 209–214. [Google Scholar]
- Leuba, S.; Stossel, P. Chitosan and other polyamines: Antifungal activity and interaction with biological membranes. In Chitin in Nature and Technology, 1st ed.; Muzzarelli, R., Jeuniaux, C., Gooday, G.W., Eds.; Plenum Press: New York, NY, USA, 1986; pp. 215–222. [Google Scholar]
- Eaton, P.; Fernandes, J.C.; Pereira, E.; Pintado, M.E.; Malcata, F.X. Atomic force microscopy study of the antibacterial effects of chitosans on Escherichia coli and Staphylococcus aureus. Ultramicroscopy 2008, 108, 1128–1134. [Google Scholar] [CrossRef] [PubMed]
- Benhabiles, M.S.; Salah, R.; Lounici, H.; Drouiche, N.; Goosen, M.F.A.; Mameri, N. Antibacterial activity of chitin, chitosan and its oligomers prepared from shrimp shell waste. Food Hydrocoll. 2012, 29, 48–56. [Google Scholar] [CrossRef]
- Zimoch-Korzycka, A.; Gardrat, C.; Castellan, A.; Coma, V.; Jarmoluk, A. The use of lysozyme to prepare biologically active chitooligomers. Polimeros 2015, 25, 35–41. [Google Scholar] [CrossRef]
- Wu, G.J.; Wu, C.H.; Tsai, G.J. Chitooligosaccharides from the shrimp chitosan hydrolysate induces differentiation of murine RAW264.7 macrophages into dendritic-like cells. J. Funct. Foods 2015, 12, 70–79. [Google Scholar] [CrossRef]
- Lin, S.B.; Lin, Y.C.; Chen, H.H. Low molecular weight chitosan prepared with the aid of cellulase, lysozyme and chitinase: Characterisation and antibacterial activity. Food Chem. 2009, 116, 47–53. [Google Scholar] [CrossRef]
- Qin, C.; Zhou, B.; Zeng, L.; Zhang, Z.; Liu, Y.; Du, Y.; Xiao, L. The physicochemical properties and antitumor activity of cellulase-treated chitosan. Food Chem. 2004, 84, 107–115. [Google Scholar] [CrossRef]
- Farinas, C.S.; Loyo, M.M.; Baraldo Junior, A.; Tardioli, P.W.; Neto, V.B.; Couri, S. Finding stable cellulase and xylanase: Evaluation of the synergistic effect of pH and temperature. New Biotechnol. 2010, 27, 810–815. [Google Scholar] [CrossRef] [PubMed]
- Kuhad, R.C.; Gupta, R.; Singh, A. Microbial cellulases and their industrial applications. Enzyme Res. 2011, 2011, 280696. [Google Scholar] [CrossRef] [PubMed]
- Il’ina, A.V.; Tkacheva, Y.V.; Varlamov, V.P. Depolymerization of high-molecular-weight chitosan by the enzyme preparation celloviridine G20x. Appl. Biochem. Microbiol. 2002, 38, 112–115. [Google Scholar] [CrossRef]
- Xie, H.; Jia, Z.; Huang, J.; Zhang, C. Preparation of low molecular weight chitosan by complex enzymes hydrolysis. Int. J. Chem. 2011, 3, 180–186. [Google Scholar] [CrossRef]
- Lee, J.M.; Heitmann, J.A.; Pawlak, J.J. Rheology of carboxymethyl cellulose solutions treated with cellulases. Bioresources 2006, 2, 20–33. [Google Scholar]
- Shen, C.R.; Liu, C.L.; Lee, H.P.; Chen, J.K. The identification and characterization of chitotriosidase activity in pancreatin from porcine pancreas. Molecules 2013, 18, 2978–2987. [Google Scholar] [CrossRef] [PubMed]
- Prior, R.; Wu, X.; Schaich, K. Standardized methods for the determination of antioxidant capacity and phenolics in foods and dietary supplements. J. Agric. Food Chem. 2005, 53, 4290–4302. [Google Scholar] [CrossRef] [PubMed]
- Ruiz-Navajas, Y.; Viuda-Martos, M.; Sendra, E.; Perez-Alvarez, J.A.; Fernández-López, J. In vitro antibacterial and antioxidant properties of chitosan edible films incorporated with Thymus moroderi or Thymus piperella essential oils. Food Control 2013, 30, 386–392. [Google Scholar] [CrossRef]
- Yen, M.T.; Yang, J.H.; Mau, J.L. Antioxidant properties of chitosan from crab shells. Carbohydr. Polym. 2008, 74, 840–844. [Google Scholar] [CrossRef]
- Yen, M.T.; Tseng, Y.H.; Li, R.C.; Mau, J.L. Antioxidant properties of fungal chitosan from shiitake stipes. LWT Food Sci. Technol. 2007, 40, 255–261. [Google Scholar] [CrossRef]
- Park, P.J.; Je, J.Y.; Kim, S.K. Free radical scavenging activity of chitooligosaccharides by electron spin resonance spectrometry. J. Agric. Food Chem. 2003, 51, 4624–4627. [Google Scholar] [CrossRef] [PubMed]
- Xie, W.M.; Xu, P.X.; Liu, Q. Antioxidant activity of water-soluble chitosan derivatives. Bioorg. Med. Chem. Lett. 2001, 11, 1699–1701. [Google Scholar] [CrossRef]
- Sun, T.; Zhu, Y.; Xie, J.; Yin, X. Antioxidant activity of N-acyl chitosan oligosaccharide with same substituting degree. Bioorg. Med. Chem. Lett. 2011, 21, 798–800. [Google Scholar] [CrossRef] [PubMed]
- Moon, J.; Shibamoto, T. Antioxidant assays for plant and food components. J. Agric. Food Chem. 2009, 57, 1655–1666. [Google Scholar] [CrossRef] [PubMed]
- Qin, Y. The chelating properties of chitosan fibers. J. Appl. Polym. Sci. 1993, 49, 727–731. [Google Scholar] [CrossRef]
- Gordon, M.H. The mechanism of antioxidant action in vitro. In Food Antioxidants, 1st ed.; Hudson, B.J.F., Ed.; Elsevier Applied Food Science: New York, NY, USA, 1990; pp. 1–18. [Google Scholar]
- Cho, H.R.; Chang, D.S.; Lee, W.D.; Jeong, E.T.; Lee, E.W. Utilization of chitosan hydrolysate as a natural food preservative for fish meat paste products. Korean J. Food Sci. Technol. 1998, 30, 817–822. [Google Scholar]
- Zimoch-Korzycka, A.; Jarmoluk, A. The use of chitosan, lysozyme, and the nano-silver as antimicrobial ingredients of edible protective hydrosols applied into the surface of meat. J. Food Sci. Technol. 2015, 52, 5996–6002. [Google Scholar] [CrossRef] [PubMed]
- Xiao, B.; Wan, Y.; Zhao, M.; Liu, Y.; Zhang, S. Preparation and characterization of antimicrobial chitosan-N-arginine with different degrees of substitution. Carbohydr. Polym. 2011, 83, 144–150. [Google Scholar] [CrossRef]
- Kong, M.; Chen, X.G.; Xing, K.; Park, H.J. Antimicrobial activity of chitosan and mode of action: A state of the art review. Int. J. Food Microbiol. 2010, 144, 51–63. [Google Scholar] [CrossRef] [PubMed]
- Kong, M.; Chen, X.G.; Liu, C.S.; Liu, C.G.; Meng, X.H.; Yu, L.J. Antibacterial mechanism of chitosan microspheres in a solid dispersing system against E. coli. Colloids Surf. B Biointerfaces 2008, 65, 197–202. [Google Scholar] [CrossRef] [PubMed]
- Miller, G.L. Use of dinitrosalicylic acid reagent for determination of reducing sugar. Anal. Chem. 1959, 31, 426–428. [Google Scholar] [CrossRef]
- Chen, J.C.; Yeh, J.Y.; Chen, P.C.; Hsu, C.K. Phenolic content and DPPH radical scavenging activity of yam-containing surimi gels influenced by salt and heating. Asian J. Health Inf. Sci. 2007, 2, 1–11. [Google Scholar]
- Benzie, I.F.F.; Strain, J.J. The ferric reducing ability of plasma (FRAP) as a measure of “antioxidant power”. Anal. Biochem. 1996, 239, 70–76. [Google Scholar] [CrossRef] [PubMed]
- Song, Y.; Babiker, E.E.; Usui, M.; Saito, A.; Kato, A. Emulsifying properties and bactericidal action of chitosan-lysozyme conjugates. Food Res. Int. 2002, 35, 459–466. [Google Scholar] [CrossRef]

| Variants Coding | Scavenging Effect of DPPH (%) | FRAP (µM Fe(II)/mL) |
|---|---|---|
| C0T0 | 7.6 ± 0.73 a,b | 61.6 ± 7.08 a |
| C0.05T0 | 9.2 ± 0.57 a,b | 71.6 ± 4.74 a,b |
| C0.1T0 | 11.5 ± 2.16 b | 87.9 ± 6.16 b,c |
| C0T3 | 6.8 ± 1.57 a | 81.6 ± 2.97 a,b,c |
| C0.05T3 | 39.5 ± 2.13 c | 161.3 ± 7.70 d |
| C0.1T3 | 45.2 ± 0.14 d | 266.2 ± 13.29 e |
| C0T20 | 5.9 ± 0.49 a | 93.6 ± 3.76 c |
| C0.05T20 | 47.1 ± 2.46 d | 275.6 ± 15.93 e |
| C0.1T20 | 52.1 ± 5.50 e | 329.4 ± 25.07 f |
| Variants Coding | Log Reduction | |||
|---|---|---|---|---|
| P. fluorescens | Y. enterocolitica | B. cereus | S. aureus | |
| C0T0 | 2.2 ± 0.26 | 0.3 ± 0.13 | 9.2 ± 0.06 | 0.9 ± 0.13 |
| C0.05T0 | 9.5 ± 0.05 | 0.3 ± 0.06 | 9.2 ± 0.06 | 2.0 ± 0.23 |
| C0.1T0 | 9.5 ± 0.05 | 0.5 ± 0.07 | 9.2 ± 0.06 | 2.2 ± 0.06 |
| C0T3 | 4.7 ± 4.12 | 0.3 ± 0.11 | 9.2 ± 0.06 | 0.9 ± 0.27 |
| C0.05T3 | 9.5 ± 0.05 | 1.5 ± 0.32 | 9.2 ± 0.06 | 1.7 ± 0.48 |
| C0.1T3 | 9.5 ± 0.05 | 9.3 ± 0.07 | 9.2 ± 0.06 | 9.2 ± 0.06 |
| C0T20 | 2.3 ± 0.23 | 0.7 ± 0.26 | 9.2 ± 0.06 | 1.4 ± 0.10 |
| C0.05T20 | 9.5 ± 0.05 | 9.3 ± 0.07 | 9.2 ± 0.06 | 9.2 ± 0.06 |
| C0.1T20 | 9.5 ± 0.05 | 9.3 ± 0.07 | 9.2 ± 0.06 | 9.2 ± 0.06 |
| Variants Coding | Variation Factors | Constant Factors | ||||
|---|---|---|---|---|---|---|
| Cellulase (%) | Time (h) | Chitosan (%) | HPMC (%) | Glycerol (%) | Lactic Acid (%) | |
| C0T0 | 0 | 0 | 1 | 1 | 25 | 0.25 |
| C0.05T0 | 0.05 | |||||
| C0.1T0 | 0.1 | |||||
| C0T3 | 0 | 3 | ||||
| C0.05T3 | 0.05 | |||||
| C0.1T3 | 0.1 | |||||
| C0T20 | 0 | 20 | ||||
| C0.05T20 | 0.05 | |||||
| C0.1T20 | 0.1 | |||||
© 2016 by the authors; licensee MDPI, Basel, Switzerland. This article is an open access article distributed under the terms and conditions of the Creative Commons Attribution (CC-BY) license (http://creativecommons.org/licenses/by/4.0/).
Share and Cite
Zimoch-Korzycka, A.; Bobak, Ł.; Jarmoluk, A. Antimicrobial and Antioxidant Activity of Chitosan/Hydroxypropyl Methylcellulose Film-Forming Hydrosols Hydrolyzed by Cellulase. Int. J. Mol. Sci. 2016, 17, 1436. https://doi.org/10.3390/ijms17091436
Zimoch-Korzycka A, Bobak Ł, Jarmoluk A. Antimicrobial and Antioxidant Activity of Chitosan/Hydroxypropyl Methylcellulose Film-Forming Hydrosols Hydrolyzed by Cellulase. International Journal of Molecular Sciences. 2016; 17(9):1436. https://doi.org/10.3390/ijms17091436
Chicago/Turabian StyleZimoch-Korzycka, Anna, Łukasz Bobak, and Andrzej Jarmoluk. 2016. "Antimicrobial and Antioxidant Activity of Chitosan/Hydroxypropyl Methylcellulose Film-Forming Hydrosols Hydrolyzed by Cellulase" International Journal of Molecular Sciences 17, no. 9: 1436. https://doi.org/10.3390/ijms17091436
APA StyleZimoch-Korzycka, A., Bobak, Ł., & Jarmoluk, A. (2016). Antimicrobial and Antioxidant Activity of Chitosan/Hydroxypropyl Methylcellulose Film-Forming Hydrosols Hydrolyzed by Cellulase. International Journal of Molecular Sciences, 17(9), 1436. https://doi.org/10.3390/ijms17091436

